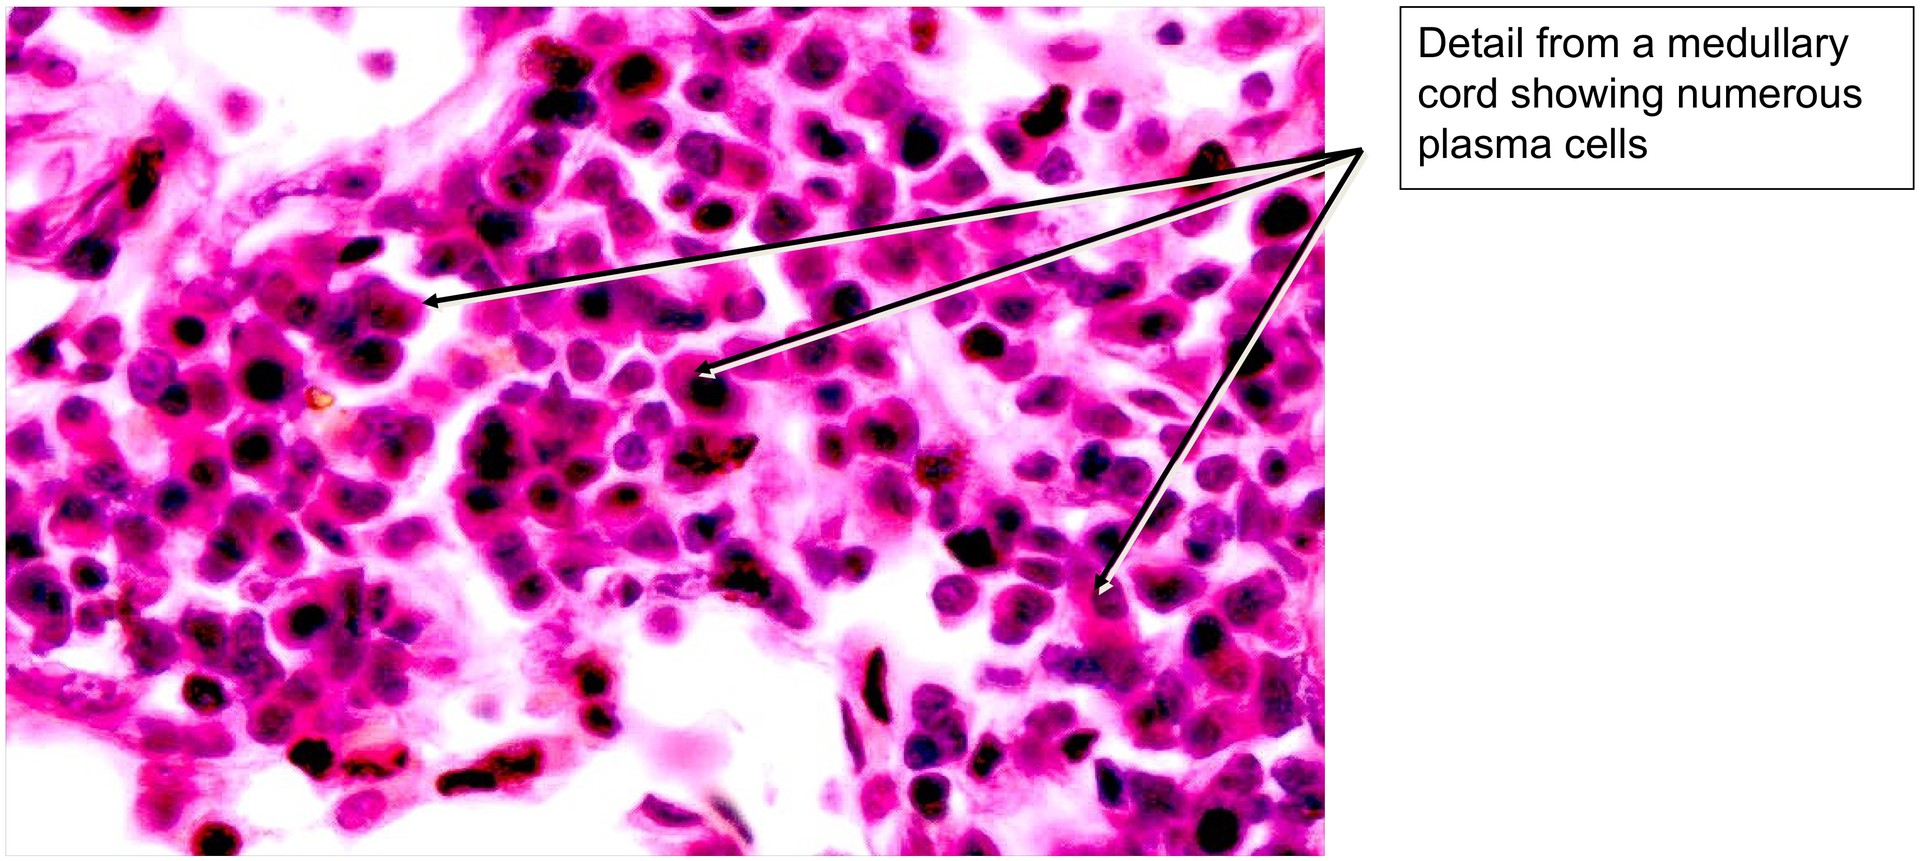
Lymph node, dog

LYMPHATIC ORGANS (ANATOMICAL MICROSCOPY)
15.2
Lymph nodes, dog
Preparation:
Preparation Details:
Organ: Lymph Node
Origin: Dog
Staining: Hematoxylin - Eosin (H&E)
Method and Specimen Description:
Conventional histological section stained with H&E for overview examination of the lymph node’s structural and cellular organization.
Objective of the Examination:
To study the architecture of a lymph node, including its stroma, reticular framework, lymphatic pathways, and parenchymal lymphatic tissue.
Special Features of the Preparation:
The lymph node is typically kidney-shaped, as seen at low magnification. It is enclosed by a connective tissue capsule from which trabeculae extend into the interior of the organ.
Multiple afferent lymphatic vessels enter the node on its convex surface, while one or two efferent vessels exit at the concave hilum. Lymph flows sequentially through:
- the marginal (subcapsular) sinus,
- the intermediate (cortical) sinuses, and
- the medullary sinuses, before leaving via the efferent vessels at the hilum.
The internal framework consists of fibroblastic reticular cells (FRCs) supported by reticular fibers. This network provides the scaffold for lymphocytes, macrophages, and other immune cells.
In the cortex, lymph follicles (the B-cell zone) are in the marginal region, whereas the paracortex below represents the T-cell zone. Within the medullary cords, plasma cells and macrophages predominate.
In this mediastinal lymph node specimen, macrophages frequently contain fine dust particles (condensate deposits), a common finding in lymph nodes draining the thoracic cavity.
When well sectioned, the lymphatic follicles display a dark mantle zone (dense small lymphocytes) surrounding a lighter germinal center. Within the germinal center, two distinct regions can often be recognized:
- a dark zone, where proliferation of antigen-stimulated B-cells occurs, and
- a light zone, where plasma cell differentiation predominates. The dark zone typically faces the adjacent paracortical T-cell area
Tasks:
- Examine the capsule and trabeculae and observe the distribution of connective tissue and blood vessels within them.
- Identify lymph follicles in the cortical region and study their organization into a lymphocyte mantle and a germinal center.
- In one or two follicles, distinguish between the dark and light zones within the germinal center.
- Locate the marginal (subcapsular) sinus, intermediate (cortical) sinuses, and medullary sinuses. Observe their wall structure and relationship to surrounding lymphatic tissue.
- Identify the paracortical zone (T-cell area).
- Search for medullary cords and identify plasma cells within them.

License
University of Basel
Downloads